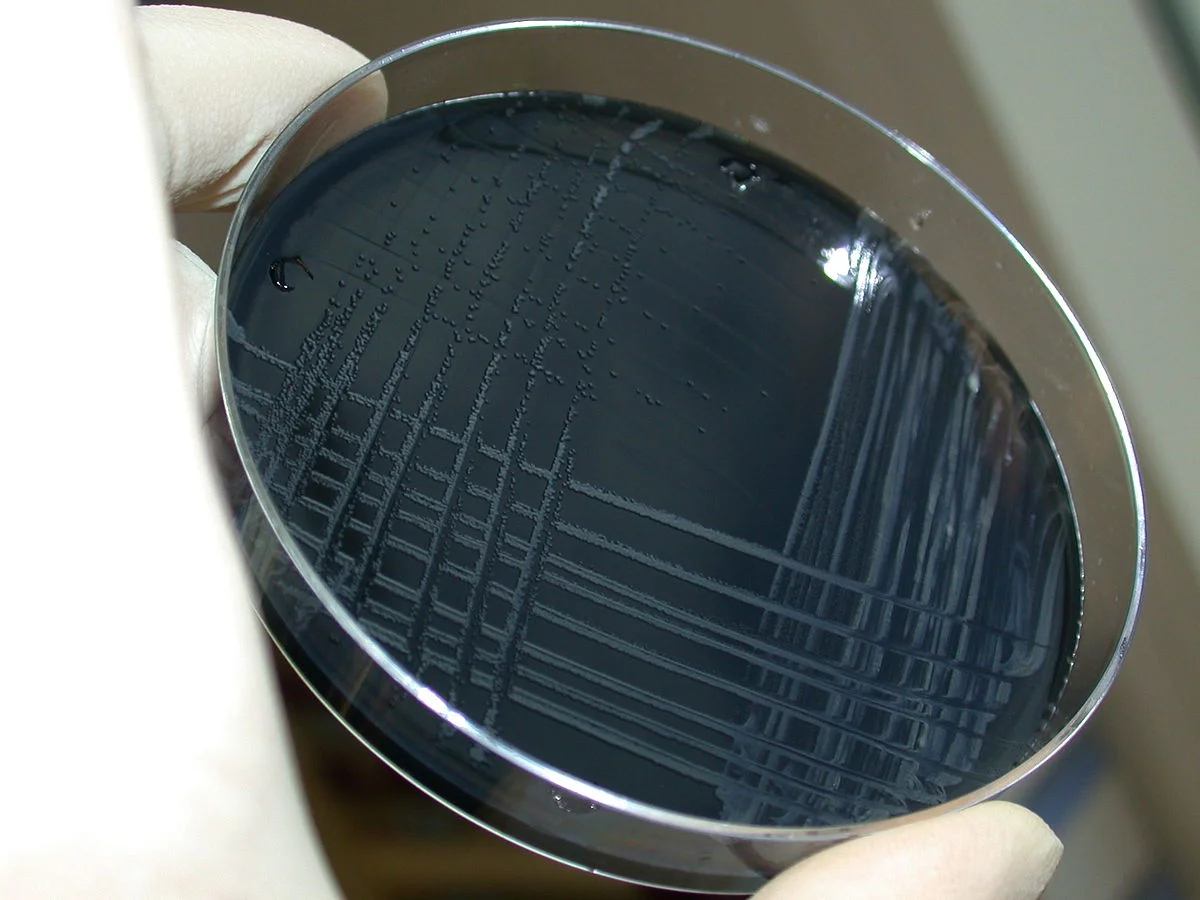
ترکیبات محیط کشت انتخابی زغال چوب
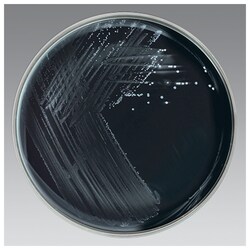
روش تهیه محیط کشت انتخابی زغال چوب

مقدمهای بر محیط کشت انتخابی زغال چوب
در سال 1984، Bolton و همکارانش اظهار داشتند که زغال چوب میتواند به طور موثری جایگزین خون در یک محیط کشت برای جداسازی گونههای کمپیلوباکتر (Campylobacter) شود. Endtz و همکارانش بعداً تأیید کردند که در هنگام استفاده از محیط کشت انتخابی زغال چوب، نرخ جداسازی کمپیلوباکتر بالاتر است.
ترکیبات محیط کشت انتخابی زغال چوب
| مواد تشکیل دهنده | گرم بر لیتر |
| عصاره گوشت گاو | 10 گرم |
| ژلاتین پپتون (Gelatin Peptone) | 10 گرم |
| کلرید سدیم (Sodium Chloride) | 5 گرم |
| کازئین پپتون (Casein Peptone) | 3 گرم |
| زغال چوب | 4 گرم |
| سدیم دزوکسیکولات (Sodium desoxycholate) | 1 گرم |
| سولفات آهن (Ferrous sulfate) | 0.25 گرم |
| سدیم پیروات (Sodium Pyruvate) | 0.25 گرم |
| سیکلوهگزیماید (Cycloheximide) | 100 میلیگرم |
| سفوپرازون (Cefoperazone) | 32 میلیگرم |
| هماتین (Hematin) | 32 میلیگرم |
| وانکومایسین (Vancomycin) | 20 میلیگرم |
| آگار | 12 گرم |
pH (در دمای 25 درجه سانتیگراد): 0.2 ± 7.4
اصول محیط کشت انتخابی زغال چوب
این محیط شامل عصاره گوشت گاو است که نیتروژن، کربوهیدراتها، ویتامینها و سایر مواد مغذی مورد نیاز برای رشد کمپیلوباکتر را تامین میکند. پپتونهای ژلاتین و کازئین مواد مغذی را به شکل اسیدهای آمینه و پپتیدها (Peptide) فراهم میکنند. زغال چوب، هماتین، پیروات سدیم و سولفات آهن باعث بهبود قابلیت تحمل هوای (aerotolerance) گونههای کمپیلوباکتر میشوند.
بیان شده که این مکملها به عنوان عوامل دفع کننده مشتقات اکسیژن سمی که بصورت فوتوشیمیایی تولید شده، عمل میکنند. زغال چوب یک عامل سمزدایی است و فشار اکسیژن را کاهش میدهد. کلرید سدیم، الکترولیتهای (Electrolyte) لازم را برای حفظ تعادل اسمزی فراهم میکند و در نتیجه یکپارچگی سلولها را حفظ میکند.
سدیم دزوکسیکولات یک محیط انتخابی است که برخی از باکتریها را مهار میکند. سفوپرازون یک آنتیبیوتیک سفالوسپورینی (Cephalosporin) است که رشد باسیلهای رودهای گرم منفی و برخی گونههای گرم مثبت را سرکوب میکند. وانکومایسین یک آنتیبیوتیک گلیکوپپتیدی (Glycopeptide) است که بسیاری از گونههای باکتریهای گرم مثبت را مهار میکند. سیکلوهگزیماید یک عامل ضد قارچی است که مخمر و کپک را مهار میکند.
روش آمادهسازی محیط کشت انتخابی زغال چوب
- عناصر ترکیب را به آب مقطر یا دیونیزه اضافه کنید و حجم را به 1000 میلیلیتر برسانید.
- محیط را کاملا مخلوط کنید. به آرامی حرارت داده و در حین هم زدن مکرر بگذارید به جوش بیاید.
- محیط را به مدت 15 دقیقه با فشار 15 psi در 121 درجه سانتیگراد اتوکلاو کنید.
- اجازه دهید که محیط تا دمای 45 تا 50 درجه سانتیگراد خنک شود.
- محیط را در ظروف پتری استریل بریزید یا در لولههای آزمایش توزیع کنید.
- بالن (Flask) را در حین توزیع تکان دهید تا زغال چوب معلق بماند.
تفسیر نتایج در محیط کشت انتخابی زغال چوب
- کمپیلوباکتر ژژونی (Jejuni) دو نوع کلنی تولید میکند.
- یکی کوچک، برجسته، قهوهای مایل به خاکستری، صاف و درخشان با لبه کامل نیمه شفاف میباشد.
- کلنی نوع دیگر مسطح، موکوئیدی (Mucoid)، نیمه شفاف، مایل به خاکستری و دارای لبه نامنظم است.
- کلنیهای مسطح، نامنظم یا در حال پخش در محیط تازه تهیه شده، مشاهده میشوند.
- برخی از سویهها به صورت لایه نازک روی آگار ظاهر میشوند یا کلونیهایی را شکل میدهند که در امتداد خطوط تلقیح رگهای قرار دارند.
- در محیطهای که تازه تهیه نشدهاند، کلنیها 1 تا 2 میلیمتر قطر داشته و گرد هستند. کلنیهای محدب و درخشان تشکیل میشوند. کلنیها میتوانند به رنگ زرد تا خاکستری یا صورتی باشند و همچنین کلنیها غیر همولیتیک (Hemolytic) هستند.
موارد استفاده از محیط کشت انتخابی زغال چوب
- برای جداسازی انتخابی و شناسایی احتمالی گونههای کمپیلوباکتر از مواد غذایی و نمونههای مدفوع انسانی استفاده میشود.
محدودیتهای محیط کشت انتخابی زغال چوب
- توصیه میشود برای شناسایی کامل، آزمایشات بیوشیمیایی، ایمونولوژیک، مولکولی یا طیفسنجی جرمی روی کلنیهای حاصل از کشت خالص انجام شود.
- ادامه انکوباسیون تا 72 ساعت ممکن است نرخ جداسازی کمپیلوباکتر را افزایش دهد.
- کمپیلوباکتر کلی (Campylobacter coli)، کمپیلوباکتر فتوس (Campylobacter fetus) و برخی از سویههای کمپیلوباکتر ژژونی توسط سفالوسپورینها مهار میشوند.
- از آنجا که کمپیلوباکتر ژژونی یک ارگانیسم گرما دوست است، انکوباسیون باید در دمای 42 درجه سانتیگراد انجام شود. دمای بالاتر با مهار میکروفلورهای (Microflora) همراه و تقویت رشد کمپیلوباکتر ژژونی باعث انتخاب شدن محیط میشود.
- عوامل موجود در یک محیط انتخابی ممکن است برخی از سویههای گونه مورد نظر را مهار کنند یا اجازه رشد گونهای را که قصد داریم رشد آن را مهار کنیم، بدهند، بهویژه اگر گونه به تعداد زیادی در نمونهها وجود داشته باشد. بنابراین نمونههای کشتشده روی محیطهای انتخابی باید روی محیطهای غیرانتخابی نیز کشت شوند تا اطلاعات بیشتری جهت اطمینان از بازیابی عوامل بیماریزای بالقوه به دست آید.
جهت خرید و یا استعلام قیمت با ما تماس بگیرید یا در واتسپ پیام بزارید
مطالب مرتبط با محیط کشت انتخابی زغال چوب:
- محیط کشت BSA: ترکیب، اصول، آمادهسازی، نتایج و کاربرد
- زاپکس آگار (محیط کشت CZA): ترکیب، اصول، آمادهسازی، نتایج و کاربرد
- محیط کشت CVA (کمپیلوباکتر بلاد آگار): ترکیب، اصول، آمادهسازی، نتایج و کاربرد
- هکتون انتریک آگار (محیط کشت HE): ترکیب، اصول، آمادهسازی و نتایج
مترجم: صادق حسینیکیا



